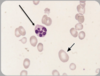
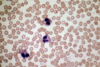
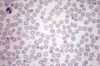
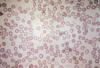
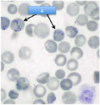

Spotter Flashcards
(197 cards)
What does this ECG show and why?

S-T depression, can be sign of chronic ischaemia
Label A-C

A: arcuate vessels
B: interlobular arteries
C: interlobar vessels
What are A, B and C?

A: posterior intercostal artery
B: lateral cutaneous branch
C: anterior intercostal artery
Label A-F around the diaphragm.

A: Aorta
B: R sympathetic trunk
C: L sympathetic trunk
D: Azygos
E: Thoracic duct
F: IVC
NB: diaphragm attachement around costal margin (inferior border of lower rib)
What changes can you see in this asthma-affected airway?

Mucous plugging
Wall thickening (inflammation)
Smooth muscle hypertrophy
What is wrong in this Xray?

Mitral valve stenosis, enlarged L atrium and pulmonary oedema.

What are the 2 main features of this CXR?

Batwing
Blunting of costophrenic angle. If fluid in pleural cavity, goes to this area due to gravity = indicitave of pleural effusion, can be caused by many things e.g. heart failure
Label A-C (with percentages)

A: plasma 55% (water 90%, solutes 10%)
B: erythrocytes (45%)
C: Leukocytes and thrombocytes (platelets)
What is this showing in the lungs and why?

Pulmonary TB
Early Mycobacterium tuberculosus - early caseous granuloma , central area of caseous necrosis (CN), surrounded by macrophages (M) which fuse to giant Langerhans cells (L). Arrows = rim of lymphocytes.
What type of ciliated epithelium is this?
What is the arrow pointing to?
What are the arrow heads pointing to?

Simple columnar
Smooth muscle
BALT
65yo male, increasing breathlessness on exertion, long history of diabetes mellitus and hypertension leading to poor renal function. Low Hb.
How would you best classify this patient’s anaemia?
What terms describe the red cell appearances?
What is the most likely reason for this patient’t anaemia?

Normocytic
Acanthocytes (burr cells), schistocytes (fragments), anisocytosis (diff shapes), poikilocytosis (diff sizes)
Erythropoietin deficiency. (Anaemia due to chronic renal failure and consequent EPO deficiency, anaemia usually normocytic with red cells showing abnormalities including spicules and “burr” cells. Red cell fragments may be seen with renal vascular disease).
What does this ECG show and why?

No P wave - atrial fibrillation (pacemaker cells firing at different times = asynchronised and no electrical activity)
What is B in the lung?

Bronchiole
What are the features on this CXR?

Pleural effusion (in e.g heart failure, lungs so saturated that fluid accumulates in pleural space. A step worse from pulm oedema.
Pulmonary oedema (fluid in intersitium)
Large cardiothoracic ratio
Chest wires
What can you see in this CXR and what does this suggest?

Visceral pleural edge, air in pleural cavity

Pneumothorax
Label A-D

A: pituitary stalk
B: hypothalamus
C: pituitary gland
D: hypothalamus
Label the parts of the sternum

A: Sternal angle
B: xiphoid process
C: manubrium
4: body
What are these structures?

Seromucous glands
What are A-F?

A: coronary sinus
B: fossa ovalis
C: tricuspid valve
D: chordae tendinae
E: papillary muscles
F: trabeculae carnae
This is a longitudinal section of foetal trachea branching into the main bronchi. What is the tissue indicated by the arrows?

Hyaline cartilage
What do these CXRs show?

Pneumothorax - in 1) clearly see L lung pulled away from side, in 2) can see R visceral pleural edge
What does this CXR show? (Normal on L)

Hyperinflation - dyspnea
Identify the 3 lung cell carcinomas.

A: small cell carcinoma (small, ovoid and densely packed, dark stained, disseminate widely)
B: squamous cell carcinoma (large esinophill cells/central whorling)
C: Adenocarcinoma (G = gland)
What are A and B?

A: azygos vein
B: hemiazygos vein